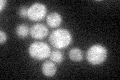
YDL112W
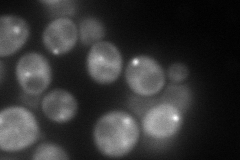
YDL112W
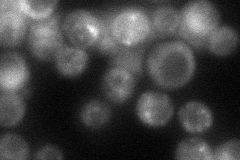
YDL112W
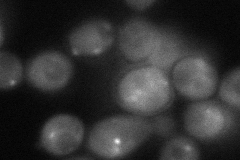
YDL112W
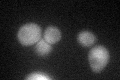
YDL112W

View description
2'-O-ribose methyltransferase, catalyzes the ribose methylation of the guanosine nucleotide at position 18 of tRNAs
Localization:
Intensity:
Fold change:
Significance:
-
C’ GFP library in SD
cytosol28.79 -
N' NOP1pr-GFP in SD

punctate148.266 -
N' TEF2pr-mCherry in SD
punctate158.299 -
N' NATIVEpr-GFP in SD
ambiguous,punctate44.7954 -
N' TEF2pr-VC and Cyto-VN in SD
cytosol,punctate64.0041 -
C’ GFP library in SD+DTT
cytosol27.560.95No -
C’ GFP library in SD+H2O2

cytosol33.111.14No -
C’ GFP library in Starvation Media

cytosol21.250.73No -
C’ GFP library on the background of Pup2-DaMP

cytosol -
C’ GFP library on the background of CCT mutant

cytosol32.45621.12692No
